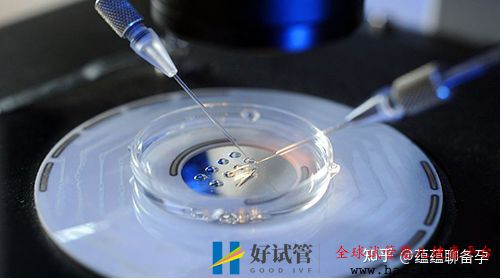
不明原因不孕让我折腾了一年,30岁终于通过试管怀上...(图5)

不明原因不孕让我折腾了一年,30岁终于通过试管怀上...
对于不孕不育患者来说,也有等级划分的,像我们这种不明原因的患者其实挺羡慕能查到明显病症的不孕患者,至少你可以对症下药。
01
我和老公是2013年底结婚的,从没做过避孕措施也一直没怀上,当时没多想,毕竟他是警察,三四天一个值班,我俩又是异地恋,只有节假日他不值班的时候才能在一起,还得排除掉姨妈期。
好巧不巧的一到国庆春节这些长假我就来大姨妈,要赶上排卵期实在太难了,眼看着我就30了,害怕会拖成高龄产妇,去年十月我心一横决定做试管婴儿,这样只要配成胚胎他人不在也可以受孕。
我们去了医院生殖科,一上来医生就给开了一大叠检查单,检查结果显示我一切正常,老公大概是经常值班作息不规律上十年的烟龄,所以精子质量不太好,但也没什么大问题,男科医生给开了调养的药。

02
我想要直接做试管,但医生说我俩没毛病不能做试管,让我先试试自然怀孕,给我开了克罗米芬促排卵,月经第五天开始吃,连吃五天,吃完每天去生殖中心b超测排卵情况,到差不多排卵那一天打一针破卵针回去跟老公同房,这个过程连续试了三个月都没怀上。
再次换了个医生想要做试管,结果医生看了我和老公的病例还是说我俩没毛病,不能直接做试管,国家规定像我这种不明原因不孕要做试管的话得先做三次人工授精还不行才能做试管。
我想想那就一步一步来,先做人工授精呗!先了做输卵管造影确保输卵管没问题,那个疼啊!最尴尬的是躺手术床上得我自己推造影剂的针筒管子,一边推一边疼得嘴直咧咧,医生还在扬声器里喊“你再推推,使劲推!”。瞬间感觉自己像个自虐狂,还好,左右两侧输卵管都是通畅的,没问题。
03
终于进入到人工授精的流程,倒霉的是第一次做人工授精恰好赶上春节医院没人,检测了大半个月的排卵最后还是被医生赶回去自己同房。
不过感觉人工授精和自然受孕的流程也差不多,还是吃促排卵的药,然后天天上医院监测排卵,到快排卵的时候打破卵针,然后喊我老公上医院取精,优化完精子后再人工注入我体内,完了开达芙通回去吃,这个流程走了两次,依然然并卵。

在我们第二次做人授还没怀上时医生问我是不是要做试管婴儿,如果要做的话可以先把试管婴儿的检查做了,因为这个检查结果需要一个多月才能出来,这样如果我们第三次人工授精还不成功的话可以无缝对接直接进入试管婴儿的流程不用再浪费时间。
第三次人工授精我卵泡长的不大就放弃了,刚好上次的检查结果出来了可以直接进入试管婴儿的流程。
04
彼时我已经从18年的冬天折腾到19年的夏天了,吃的克罗米芬和达芙通都是激素类的药,会发胖,短短半年多的时间我长了快二十斤。
老公一直骗我说我还是最漂亮的,但面对才买不久就嫌小的衣服我心里难道没有一点逼数吗?
我甚至羡慕那些能查到明显病症的不孕患者,至少知道自己哪里有问题才能治啊!
好不容易撑到取卵那天,终于要结束每天打促排针和做b超监测排卵的日子了,前一天晚上得按点打夜针,类似破卵针,第二天取卵。取卵我是不怕的,可以全麻,就是怕取完卵会有腹水之类的并发症。我取了九个卵,之后几天不停地喝水,不断上厕所,还好,没有出现腹水,却出现了另一个致命性的打击。
几天后收到了医院的短信,说我们只配成了三个胚胎!一个一级的,一个二级的,一个三级的,我心情一下就沉入谷底,怎么就只成了三个呢!而且一级的只有一个!也不能养囊了,如果一级的不成功那后面二级三级的还有什么指望呢?等于我就只有一次机会了,要是不成功又得进入天天打促排针b超监测排卵的痛苦日子了!
05
怀着忐忑的心情去移植胚胎,移植是做腹超,要憋尿,我子宫位置靠后,明明已经喝了不少水了b超仪上还是看不清,又被赶出去继续喝水,折腾了好久,第一个进手术室的我到最后一个才做。
终于移植完了,医生指着b超仪说“这个就是你的宝宝,祝你好孕!”那一瞬间突然就觉得“啊,好神奇,那个就是宝宝啊!”又躺了半小时才出来,我妈说我老公都紧张死了。
移植刚过几天有点肚子疼,还便血了,把我吓坏了,心想完了完了,估计这次又不成功了。

等待验孕棒出结果的那两分钟我感觉特别漫长,当看到两条杠时我都蒙了。
知道消息的老公高兴得快哭了,又发了个朋友圈“千呼万唤始出来”,去年我成功生下了自己的宝宝,嗯,是真的太不容易了。
做试管婴儿的那一年多我也不记得自己跑了多少趟医院,打了多少次针,承受了多少次失望,可能后来支撑着我不放弃的已经不是母性而是执着了,付出了这么多,此刻放弃那我之前的努力都白费了,抱着这样的信念才坚持了下来!
现在我的宝宝平安健康的来到了这个世界上,不枉费我和他(她)爹这么爱他(她)。





